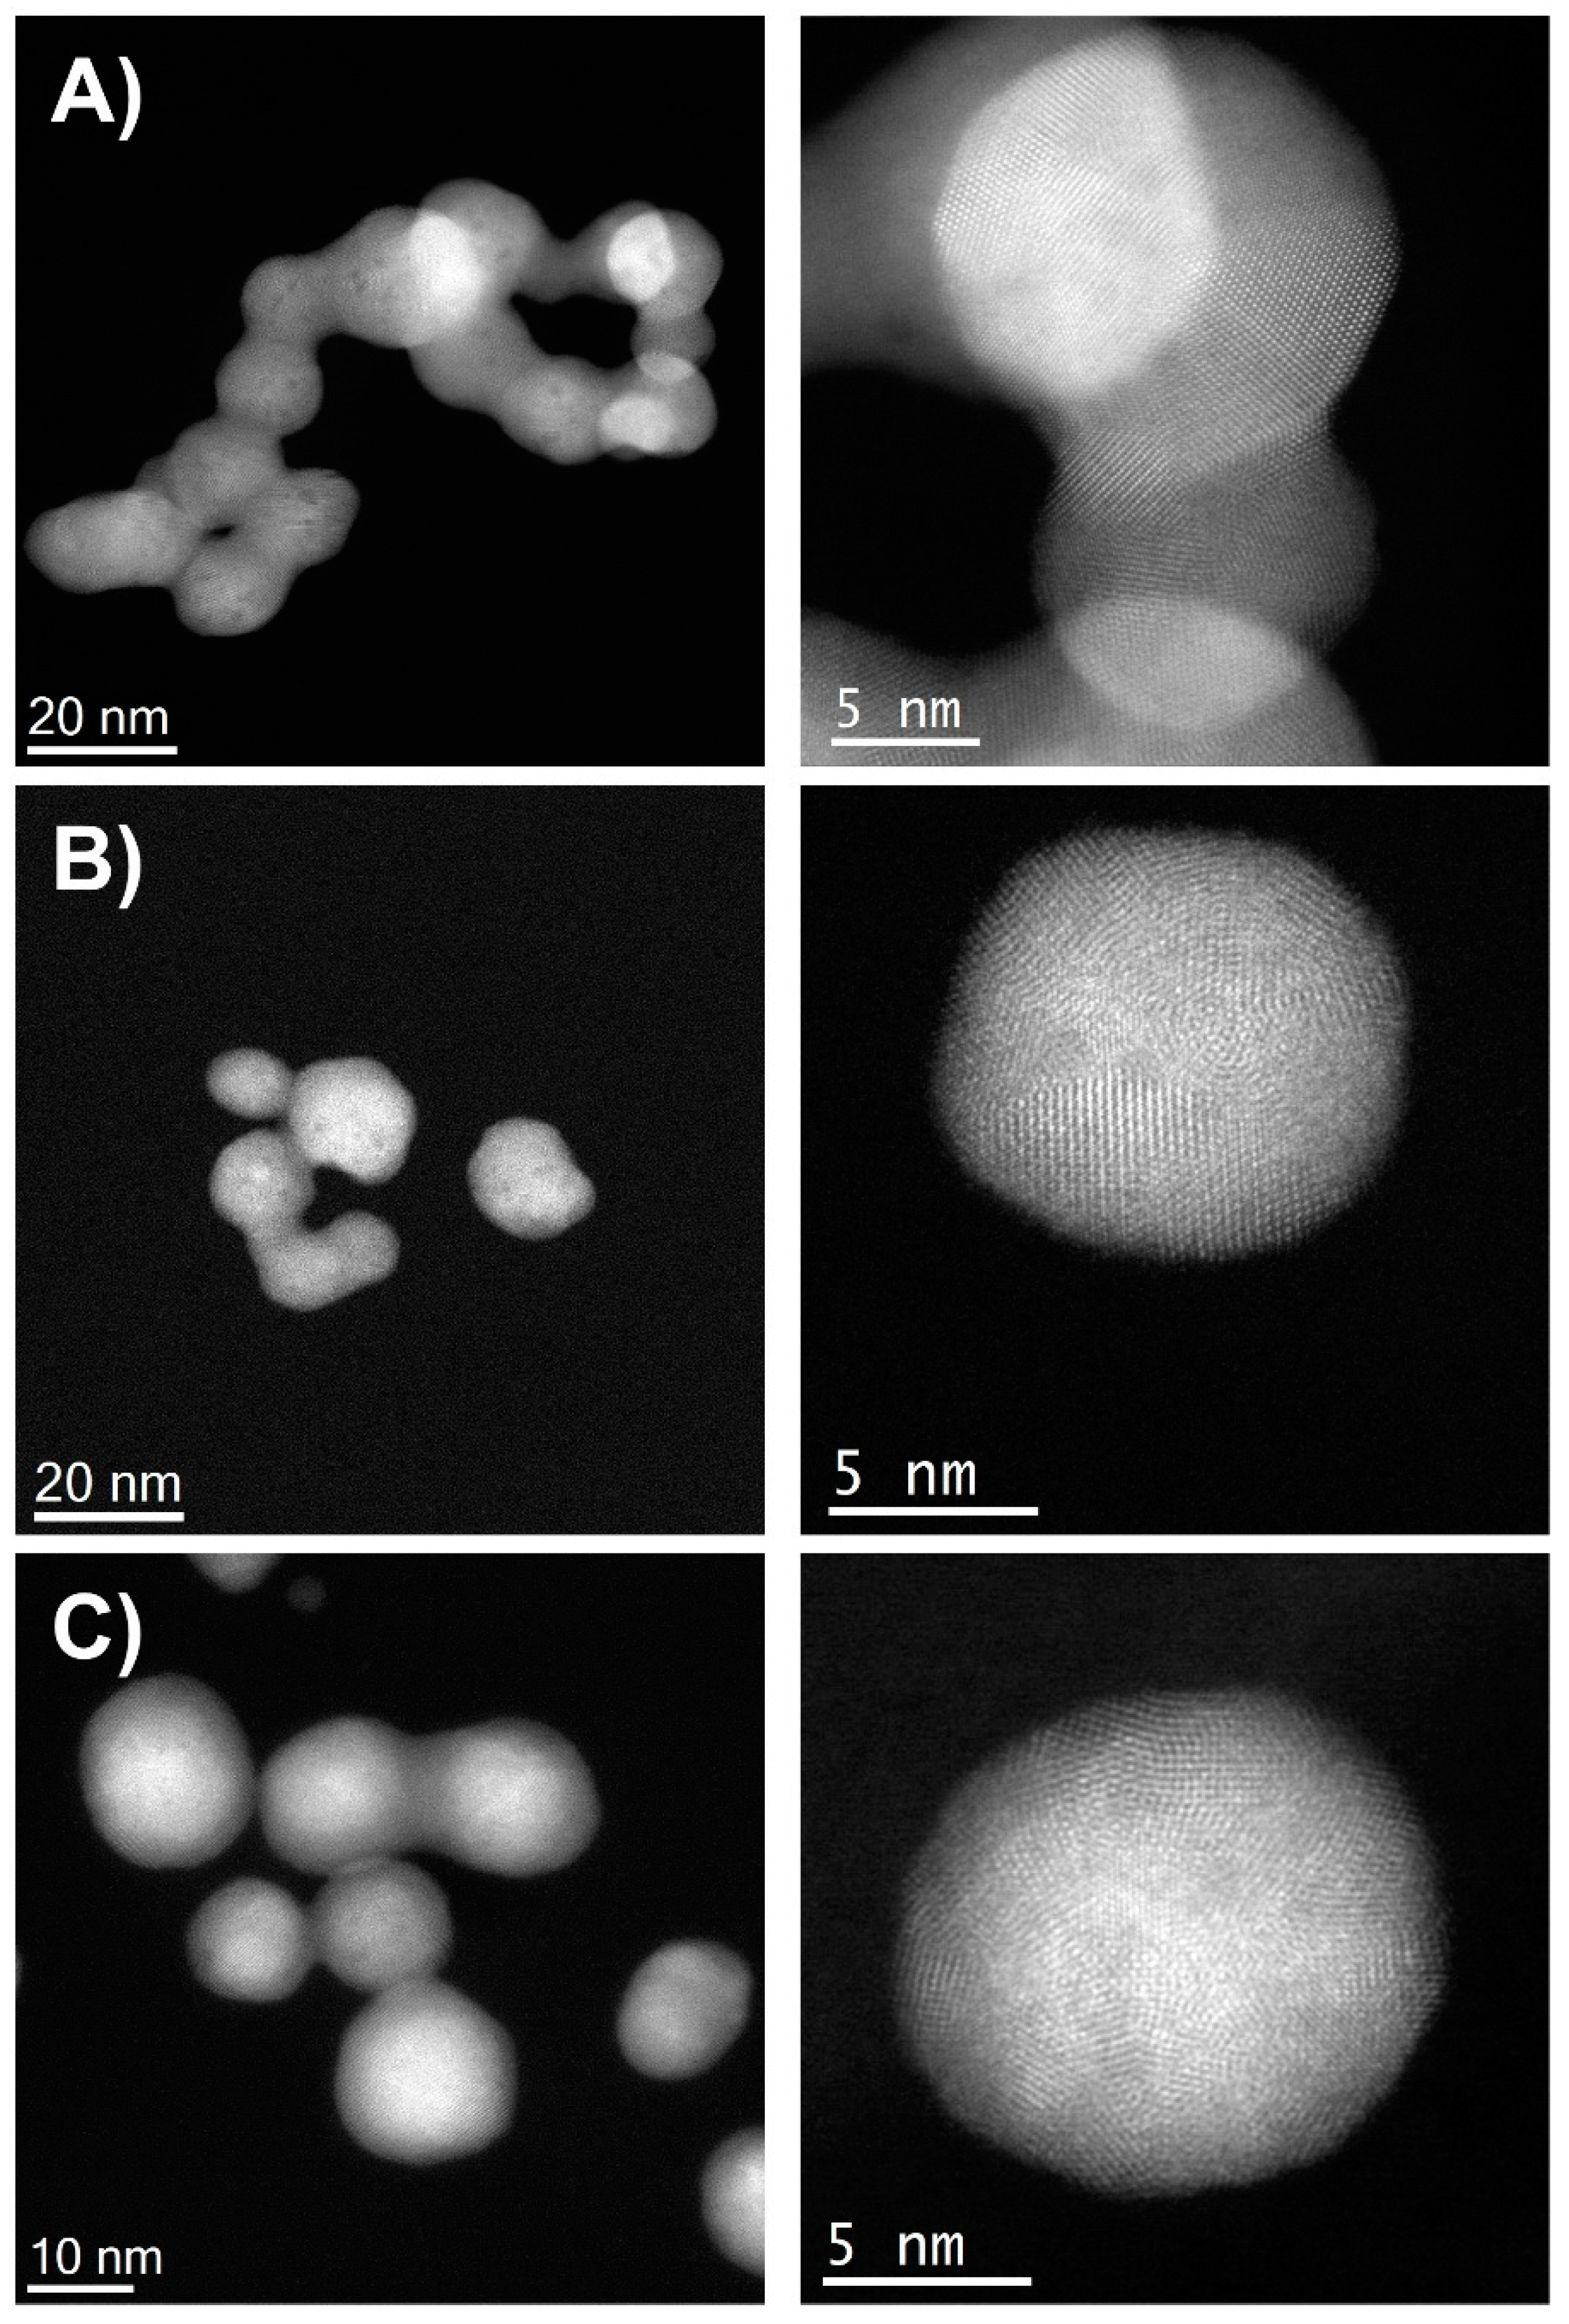
Nanomaterials 12 00779 g004

Composition-Dependent Cytotoxic and Antibacterial Activity of Biopolymer-Capped Ag/Au Bimetallic Nanoparticles against Melanoma and Multidrug-Resistant Pathogens
Abstract
:1. Introduction
2. Materials and Methods
2.1. Chemicals
2.2. Colloidal Ag/Au-NPs Synthesis
2.3. Characterization Techniques
2.3.1. UV-Visible Spectroscopy
2.3.2. FDTD Modelling
2.3.3. X-ray Diffraction Analysis
2.3.4. Fourier Transform Infrared Spectroscopy
2.3.5. Inductively Coupled Plasma Mass Spectrometry
2.3.6. X-ray Photoelectron Spectroscopy
2.3.7. Scanning Transmission Electron Microscopy
2.4. Biomedical Properties Study
2.4.1. In Vitro Antimicrobial Studies
2.4.2. Determination of the Minimum Inhibitory Concentration
2.4.3. In Vitro Cytotoxicity Studies
2.4.4. In Vitro Mechanistic Studies
2.4.5. Statistical Analysis
3. Results and Discussion
3.1. Synthesis and Optical Properties of Colloidal Bimetallic Ag/Au-NPs
3.2. Starch as a Capping Agent Characterized by FTIR Spectroscopy
3.3. Structural Characterization Using XRD
3.4. Particle Size and Morphology Characterization by STEM Analysis
3.5. Elemental Chemical Composition Analysis by ICP-MS, XPS and EDX
3.6. Antibacterial Properties of Ag/Au-NPs
3.7. Anticancer Activity of Ag/Au-NPs
4. Conclusions
Supplementary Materials
Author Contributions
Funding
Institutional Review Board Statement
Informed Consent Statement
Data Availability Statement
Acknowledgments
Conflicts of Interest
References
- Siegel, R.L.; Miller, K.D.; Jemal, A. Cancer statistics, 2020. CA. Cancer J. Clin. 2020, 70, 7–30. [Google Scholar] [CrossRef] [PubMed]
- National Cancer Institute—Cancer Statistics. Available online: https://www.cancer.gov/about-cancer/understanding/statistics (accessed on 14 June 2021).
- Ferlay, J.; Laversanne, M.; Ervik, M.; Lam, F.; Colombet, M.; Mery, L.; Piñeros, M.; Znaor, A.; Soerjomataram, I.B.F. Global Cancer Observatory: Cancer Tomorrow. Available online: https://gco.iarc.fr/tomorrow (accessed on 14 July 2021).
- Maeda, H.; Khatami, M. Analyses of repeated failures in cancer therapy for solid tumors: Poor tumor-selective drug delivery, low therapeutic efficacy and unsustainable costs. Clin. Trans. Med. 2018, 7, 11. [Google Scholar] [CrossRef] [PubMed]
- Housman, G.; Byler, S.; Heerboth, S.; Lapinska, K.; Longacre, M.; Snyder, N.; Sarkar, S. Drug resistance in cancer: An overview. Cancers 2014, 6, 1769. [Google Scholar] [CrossRef] [PubMed] [Green Version]
- CDC. Antibiotic Resistance Threats in the United States; CDC: Atlanta, GA, USA, 2019.
- Hassoun, A.; Linden, P.K.; Friedman, B. Incidence, prevalence, and management of MRSA bacteremia across patient populations—A review of recent developments in MRSA management and treatment. Crit. Care 2017, 21, 211. [Google Scholar] [CrossRef] [Green Version]
- Borg, M.A. Bed occupancy and overcrowding as determinant factors in the incidence of MRSA infections within general ward settings. J. Hosp. Infect. 2003, 54, 316–318. [Google Scholar] [CrossRef]
- Shrestha, P.; Cooper, B.S.; Coast, J.; Oppong, R.; Do Thi Thuy, N.; Phodha, T.; Celhay, O.; Guerin, P.J.; Wertheim, H.; Lubell, Y. Enumerating the economic cost of antimicrobial resistance per antibiotic consumed to inform the evaluation of interventions affecting their use. Antimicrob. Resist. Infect. Control 2018, 7, 98. [Google Scholar] [CrossRef] [Green Version]
- Dadgostar, P. Antimicrobial resistance: Implications and costs. Infect. Drug Resist. 2019, 12, 3903–3910. [Google Scholar] [CrossRef] [Green Version]
- WHO. No Time to Wait: Securing the Future from Drug-Resistant Infections Report to the Secretary-General of the United Nations; WHO: Geneva, Switzerland, 2019. [Google Scholar]
- Ahmad, M.; Khan, A.U. Global economic impact of antibiotic resistance: A review. J. Glob. Antimicrob. Resist. 2019, 19, 313–316. [Google Scholar] [CrossRef]
- Emerich, D.F.; Thanos, C.G. Nanotechnology and medicine. Expert Opin. Biol. Ther. 2003, 3, 655–663. [Google Scholar] [CrossRef]
- Liu, Y.; Solomon, M.; Achilefu, S. Perspectives and potential applications of nanomedicine in breast and prostate cancer. Med. Res. Rev. 2013, 33, 3–32. [Google Scholar] [CrossRef]
- Satalkar, P.; Elger, B.S.; Shaw, D.M. Defining Nano, Nanotechnology and Nanomedicine: Why Should It Matter? Sci. Eng. Ethics 2016, 22, 1255–1276. [Google Scholar] [CrossRef] [PubMed]
- Wang, L.; Hu, C.; Shao, L. The antimicrobial activity of nanoparticles: Present situation and prospects for the future. Int. J. Nanomed. 2017, 12, 1227. [Google Scholar]
- Nasrollahzadeh, M.; Sajjadi, M.; Sajadi, S.M.; Issaabadi, Z. (Eds.) Green Nanotechnology. In An Introduction to Green Nanotechnology; Elservier: London, UK; Oxford, UK; Cambridge, UK; San Diego, CA, USA, 2019; pp. 145–198. [Google Scholar]
- Jacob, J.M.; Lens, P.N.L.; Balakrishnan, R.M. Microbial synthesis of chalcogenide semiconductor nanoparticles: A review. Microb. Biotechnol. 2016, 9, 11–21. [Google Scholar] [CrossRef] [PubMed]
- Shi, J.; Kantoff, P.W.; Wooster, R.; Farokhzad, O.C. Cancer nanomedicine: Progress, challenges and opportunities. Nat. Rev. Cancer 2017, 17, 20–37. [Google Scholar] [CrossRef] [PubMed]
- Brown, C.D.; Medina Cruz, D.; Roy, A.K.; Webster, T.J. Synthesis and characterization of PVP-coated tellurium nanorods and their antibacterial and anticancer properties. J. Nanopart. Res. 2018, 20, 254. [Google Scholar] [CrossRef]
- Bahadar, H.; Maqbool, F.; Niaz, K.; Abdollahi, M. Toxicity of nanoparticles and an overview of current experimental models. Iran. Biomed. J. 2016, 20, 1–11. [Google Scholar] [CrossRef]
- Jadoun, S.; Arif, R.; Jangid, N.K.; Meena, R.K. Green synthesis of nanoparticles using plant extracts: A review. Environ. Chem. Lett. 2021, 19, 355–374. [Google Scholar] [CrossRef]
- Salem, S.S.; Fouda, A. Green Synthesis of Metallic Nanoparticles and Their Prospective Biotechnological Applications: An Overview. Biol. Trace Elem. Res. 2021, 199, 344–370. [Google Scholar] [CrossRef]
- Medina Cruz, D.; Mi, G.; Webster, T.J. Synthesis and characterization of biogenic selenium nanoparticles with antimicrobial properties made by Staphylococcus aureus, methicillin-resistant Staphylococcus aureus (MRSA), Escherichia coli, and Pseudomonas aeruginosa. J. Biomed. Mater. Res. Part A 2018, 106, 1400–1412. [Google Scholar] [CrossRef]
- Srivastava, P.; Gunawan, C.; Soeriyadi, A.; Amal, R.; Hoehn, K.; Marquis, C. In Vitro coronal protein signatures and biological impact of silver nanoparticles synthesized with different natural polymers as capping agents. Nanoscale Adv. 2021, 3, 4424–4439. [Google Scholar] [CrossRef]
- Meena Kumari, M.; Jacob, J.; Philip, D. Green synthesis and applications of Au-Ag bimetallic nanoparticles. Spectrochim. Acta Part A Mol. Biomol. Spectrosc. 2015, 137, 185–192. [Google Scholar] [CrossRef] [PubMed]
- Shanmugasundaram, T.; Radhakrishnan, M.; Gopikrishnan, V.; Kadirvelu, K.; Balagurunathan, R. Biocompatible silver, gold and silver/gold alloy nanoparticles for enhanced cancer therapy: In Vitro and in vivo perspectives. Nanoscale 2017, 9, 16773–16790. [Google Scholar] [CrossRef] [PubMed]
- Panicker, S.; Ahmady, I.M.; Han, C.; Chehimi, M.; Mohamed, A.A. On demand release of ionic silver from gold-silver alloy nanoparticles: Fundamental antibacterial mechanisms study. Mater. Today Chem. 2020, 16, 100237. [Google Scholar] [CrossRef]
- Botha, T.L.; Elemike, E.E.; Horn, S.; Onwudiwe, D.C.; Giesy, J.P.; Wepener, V. Cytotoxicity of Ag, Au and Ag-Au bimetallic nanoparticles prepared using golden rod (Solidago canadensis) plant extract. Sci. Rep. 2019, 9, 4169. [Google Scholar] [CrossRef] [Green Version]
- Köller, M.; Sengstock, C.; Motemani, Y.; Khare, C.; Buenconsejo, P.J.S.; Geukes, J.; Schildhauer, T.A.; Ludwig, A. Antibacterial activity of microstructured Ag/Au sacrificial anode thin films. Mater. Sci. Eng. C 2015, 46, 276–280. [Google Scholar] [CrossRef]
- Köller, M.; Bellova, P.; Javid, S.M.; Motemani, Y.; Khare, C.; Sengstock, C.; Tschulik, K.; Schildhauer, T.A.; Ludwig, A. Antibacterial activity of microstructured sacrificial anode thin films by combination of silver with platinum group elements (platinum, palladium, iridium). Mater. Sci. Eng. C 2017, 74, 536–541. [Google Scholar] [CrossRef]
- Dowling, D.P.; Betts, A.J.; Pope, C.; McConnell, M.L.; Eloy, R.; Arnaud, M.N. Anti-bacterial silver coatings exhibiting enhanced activity through the addition of platinum. Surf. Coatings Technol. 2003, 163–164, 637–640. [Google Scholar] [CrossRef]
- Elemike, E.E.; Onwudiwe, D.C.; Nundkumar, N.; Singh, M.; Iyekowa, O. Green synthesis of Ag, Au and Ag-Au bimetallic nanoparticles using Stigmaphyllon ovatum leaf extract and their in vitro anticancer potential. Mater. Lett. 2019, 243, 148–152. [Google Scholar] [CrossRef]
- Gopinath, K.; Kumaraguru, S.; Bhakyaraj, K.; Mohan, S.; Venkatesh, K.S.; Esakkirajan, M.; Kaleeswarran, P.; Alharbi, N.S.; Kadaikunnan, S.; Govindarajan, M.; et al. Green synthesis of silver, gold and silver/gold bimetallic nanoparticles using the Gloriosa superba leaf extract and their antibacterial and antibiofilm activities. Microb. Pathog. 2016, 101, 1–11. [Google Scholar] [CrossRef]
- Bankura, K.; Maity, D.; Mollick, M.M.R.; Mondal, D.; Bhowmick, B.; Roy, I.; Midya, T.; Sarkar, J.; Rana, D.; Acharya, K.; et al. Antibacterial activity of Ag-Au alloy NPs and chemical sensor property of Au NPs synthesized by dextran. Carbohydr. Polym. 2014, 107, 151–157. [Google Scholar] [CrossRef]
- Lomelí-Marroquín, D.; Medina Cruz, D.; Nieto-Argüello, A.; Vernet Crua, A.; Chen, J.; Torres-Castro, A.; Webster, T.J.; Cholula-Díaz, J.L. Starch-mediated synthesis of mono- and bimetallic silver/gold nanoparticles as antimicrobial and anticancer agents. Int. J. Nanomed. 2019, 14, 2171–2190. [Google Scholar] [CrossRef] [PubMed] [Green Version]
- Nieto-Argüello, A.; Torres-Castro, A.; Villaurrutia-Arenas, R.; Martínez-Sanmiguel, J.J.; Ujué González, M.; García-Martín, J.M.; Cholula-Díaz, J.L. Green synthesis and characterization of gold-based anisotropic nanostructures using bimetallic nanoparticles as seeds. Dalt. Trans. 2021, 50, 16923–16928. [Google Scholar] [CrossRef] [PubMed]
- Padilla-Cruz, A.L.; Garza-Cervantes, J.A.; Vasto-Anzaldo, X.G.; García-Rivas, G.; León-Buitimea, A.; Morones-Ramírez, J.R. Synthesis and design of Ag–Fe bimetallic nanoparticles as antimicrobial synergistic combination therapies against clinically relevant pathogens. Sci. Rep. 2021, 11, 5351. [Google Scholar] [CrossRef] [PubMed]
- Zhao, X.; Jia, Y.; Dong, R.; Deng, J.; Tang, H.; Hu, F.; Liu, S.; Jiang, X. Bimetallic nanoparticles against multi-drug resistant bacteria. Chem. Commun. 2020, 56, 10918–10921. [Google Scholar] [CrossRef]
- Maier, S.A. Plasmonics: Fundamentals and Applications; Springer: New York, NY, USA, 2007; ISBN 9780387378251. [Google Scholar]
- Peña-Rodríguez, O.; Caro, M.; Rivera, A.; Olivares, J.; Perlado, J.M.; Caro, A. Optical properties of Au-Ag alloys: An ellipsometric study. Opt. Mater. Express 2014, 4, 403. [Google Scholar] [CrossRef] [Green Version]
- Johnson, P.B.; Christy, R.W. Optical Constants of the Noble Metals. Phys. Rev. B 1972, 6, 4370. [Google Scholar] [CrossRef]
- Palik, E.D. (Ed.) Handbook of Optical Constants of Solids. In Handbook of Optical Constants of Solids; Academic Press: Boston, MA, USA, 1991; p. iv. ISBN 978-0-12-544422-4. [Google Scholar]
- Lambert, R.J.W.; Pearson, J. Susceptibility testing: Accurate and reproducible minimum inhibitory concentration (MIC) and non-inhibitory concentration (NIC) values. J. Appl. Microbiol. 2000, 88, 784–790. [Google Scholar] [CrossRef]
- Unser, S.; Bruzas, I.; He, J.; Sagle, L. Localized surface plasmon resonance biosensing: Current challenges and approaches. Sensors 2015, 15, 15684. [Google Scholar] [CrossRef]
- Mallin, M.P.; Murphy, C.J. Solution-Phase Synthesis of Sub-10 nm Au − Ag Alloy Nanoparticles. Nano Lett. 2002, 2, 1235–1237. [Google Scholar] [CrossRef]
- Pal, A.; Shah, S.; Kulkarni, V.; Murthy, R.S.R.; Devi, S. Template free synthesis of silver-gold alloy nanoparticles and cellular uptake of gold nanoparticles in Chinese Hamster Ovary cell. Mater. Chem. Phys. 2009, 113, 276–282. [Google Scholar] [CrossRef]
- Ristig, S.; Prymak, O.; Loza, K.; Gocyla, M.; Meyer-Zaika, W.; Heggen, M.; Raabe, D.; Epple, M. Nanostructure of wet-chemically prepared, polymer-stabilized silver-gold nanoalloys (6 nm) over the entire composition range. J. Mater. Chem. B 2015, 3, 4654–4662. [Google Scholar] [CrossRef] [PubMed] [Green Version]
- Zong, R.; Wang, X.; Shi, S.; Zhu, Y. Kinetically controlled seed-mediated growth of narrow dispersed silver nanoparticles up to 120 nm: Secondary nucleation, size focusing, and Ostwald ripening. Phys. Chem. Chem. Phys. 2014, 16, 4236–4241. [Google Scholar] [CrossRef] [PubMed]
- Bastús, N.G.; Merkoçi, F.; Piella, J.; Puntes, V. Synthesis of highly monodisperse citrate-stabilized silver nanoparticles of up to 200 nm: Kinetic control and catalytic properties. Chem. Mater. 2014, 26, 2836–2846. [Google Scholar] [CrossRef]
- Ban, D.K.; Pratihar, S.K.; Paul, S. Controlled modification of starch in the synthesis of gold nanoparticles with tunable optical properties and their application in heavy metal sensing. RSC Adv. 2015, 5, 81554–81564. [Google Scholar] [CrossRef]
- Zamiri, R.; Zakaria, A.; Ahangar, H.A.; Darroudi, M.; Zamiri, G.; Rizwan, Z.; Drummen, G.P.C. The effect of laser repetition rate on the LASiS synthesis of biocompatible silver nanoparticles in aqueous starch solution. Int. J. Nanomed. 2013, 8, 233–244. [Google Scholar] [CrossRef] [Green Version]
- Rioux, D.; Vallières, S.; Besner, S.; Muñoz, P.; Mazur, E.; Meunier, M. An analytic model for the dielectric function of Au, Ag, and their Alloys. Adv. Opt. Mater. 2014, 2, 176–182. [Google Scholar] [CrossRef]
- Kizil, R.; Irudayaraj, J.; Seetharaman, K. Characterization of irradiated starches by using FT-Raman and FTIR spectroscopy. J. Agric. Food Chem. 2002, 50, 3912–3918. [Google Scholar] [CrossRef]
- Fang, J.M.; Fowler, P.A.; Tomkinson, J.; Hill, C.A.S. The preparation and characterisation of a series of chemically modified potato starches. Carbohydr. Polym. 2002, 47, 245–252. [Google Scholar] [CrossRef]
- Suh, I.-K.; Ohta, H.; Waseda, Y. High-temperature thermal expansion of six metallic elements measured by dilatation method and X-ray diffraction. J. Mater. Sci. 1988, 23, 757–760. [Google Scholar] [CrossRef]
- Bragg, W.H.; Bragg, W.L. The reflection of X-rays by crystals. Proc. R. Soc. A 1913, 88, 428–438. [Google Scholar] [CrossRef]
- Lubarda, V.A. On the effective lattice parameter of binary alloys. Mech. Mater. 2003, 35, 53–68. [Google Scholar] [CrossRef]
- Grasmik, V.; Rurainsky, C.; Loza, K.; Evers, M.V.; Prymak, O.; Heggen, M.; Tschulik, K.; Epple, M. Deciphering the Surface Composition and the Internal Structure of Alloyed Silver–Gold Nanoparticles. Chem. A Eur. J. 2018, 24, 9051–9060. [Google Scholar] [CrossRef] [PubMed]
- Kahouli, M.; Barhoumi, A.; Bouzid, A.; Al-Hajry, A.; Guermazi, S. Structural and optical properties of ZnO nanoparticles prepared by direct precipitation method. Superlattices Microstruct. 2015, 85, 7–23. [Google Scholar] [CrossRef]
- Liu, W.; Han, W.; Zhang, M.; Guo, Z. Self-regeneration performance and characterization of Silver-Containing activated carbon fibers coated by titanium dioxide. Polymers 2019, 11, 983. [Google Scholar] [CrossRef] [Green Version]
- Camci, M.T.; Ulgut, B.; Kocabas, C.; Suzer, S. In-Situ XPS Monitoring and Characterization of Electrochemically Prepared Au Nanoparticles in an Ionic Liquid. ACS Omega 2017, 2, 478–486. [Google Scholar] [CrossRef]
- Martínez, L.; Díaz, M.; Román, E.; Ruano, M.; Llamosa P., D.; Huttel, Y. Generation of nanoparticles with adjustable size and controlled stoichiometry: Recent advances. Langmuir 2012, 28, 11241–11249. [Google Scholar] [CrossRef] [PubMed]
- Watson, R.E.; Hudis, J.; Perlman, M.L. Charge flow and d compensation in gold alloys. Phys. Rev. B 1971, 4, 4139–4144. [Google Scholar] [CrossRef]
- Malathi, S.; Ezhilarasu, T.; Abiraman, T.; Balasubramanian, S. One pot green synthesis of Ag, Au and Au-Ag alloy nanoparticles using isonicotinic acid hydrazide and starch. Carbohydr. Polym. 2014, 111, 734–743. [Google Scholar] [CrossRef]
- Harikumar, K.R.; Ghosh, S.; Rao, C.N.R. X-ray photoelectron spectroscopic investigations of Cu-Ni, Au-Ag, Ni-Pd, and Cu-Pd bimetallic clusters. J. Phys. Chem. A 1997, 101, 536–540. [Google Scholar] [CrossRef]
- Lin, Z.; Luo, Y.; Liu, P.; Li, Y.; Yue, J.; Jiang, L. Atomic-engineering Au-Ag nanoalloys for screening antimicrobial agents with low toxicity towards mammalian cells. Colloids Surfaces B Biointerfaces 2021, 204, 111831. [Google Scholar] [CrossRef]
- Padmos, J.D.; Langman, M.; MacDonald, K.; Comeau, P.; Yang, Z.; Filiaggi, M.; Zhang, P. Correlating the atomic structure of bimetallic silver gold nanoparticles to their antibacterial and cytotoxic activities. J. Phys. Chem. C 2015, 119, 7472–7482. [Google Scholar] [CrossRef]
- Kumar, S.; Majhi, R.K.; Singh, A.; Mishra, M.; Tiwari, A.; Chawla, S.; Guha, P.; Satpati, B.; Mohapatra, H.; Goswami, L.; et al. Carbohydrate-Coated Gold-Silver Nanoparticles for Efficient Elimination of Multidrug Resistant Bacteria and in vivo Wound Healing. ACS Appl. Mater. Interfaces 2019, 11, 42998–43017. [Google Scholar] [CrossRef] [PubMed]
- Mukha, I.; Vityuk, N.; Grodzyuk, G.; Shcherbakov, S.; Lyberopoulou, A.; Efstathopoulos, E.P.; Gazouli, M. Anticancer Effect of Ag, Au, and Ag/Au Bimetallic Nanoparticles Prepared in the Presence of Tryptophan. J. Nanosci. Nanotechnol. 2017, 17, 8987–8994. [Google Scholar] [CrossRef]
- Onodera, A.; Nishiumi, F.; Kakiguchi, K.; Tanaka, A.; Tanabe, N.; Honma, A.; Yayama, K.; Yoshioka, Y.; Nakahira, K.; Yonemura, S.; et al. Short-Term changes in intracellular ROS localisation after the silver nanoparticles exposure depending on particle size. Toxicol. Rep. 2015, 2, 574–579. [Google Scholar] [CrossRef] [PubMed] [Green Version]
- Shrivastava, R.; Kushwaha, P.; Bhutia, Y.C.; Flora, S.J.S. Oxidative stress following exposure to silver and gold nanoparticles in mice. Toxicol. Ind. Health 2016, 32, 1391–1404. [Google Scholar] [CrossRef] [PubMed]

| Ag/Au-NPs Sample | MIC MDR-EC (µg/mL) | MIC MRSA (µg/mL) |
|---|---|---|
| 20:80 | 20.8 | 18.1 |
| 40:60 | 18.5 | 16.3 |
| 60:40 | 5.3 | 10.2 |
| 80:20 | 4.5 | 7.9 |
Publisher’s Note: MDPI stays neutral with regard to jurisdictional claims in published maps and institutional affiliations. |
© 2022 by the authors. Licensee MDPI, Basel, Switzerland. This article is an open access article distributed under the terms and conditions of the Creative Commons Attribution (CC BY) license (https://creativecommons.org/licenses/by/4.0/).
Share and Cite
Nieto-Argüello, A.; Medina-Cruz, D.; Pérez-Ramírez, Y.S.; Pérez-García, S.A.; Velasco-Soto, M.A.; Jafari, Z.; De Leon, I.; González, M.U.; Huttel, Y.; Martínez, L.; et al. Composition-Dependent Cytotoxic and Antibacterial Activity of Biopolymer-Capped Ag/Au Bimetallic Nanoparticles against Melanoma and Multidrug-Resistant Pathogens. Nanomaterials 2022, 12, 779. https://doi.org/10.3390/nano12050779
Nieto-Argüello A, Medina-Cruz D, Pérez-Ramírez YS, Pérez-García SA, Velasco-Soto MA, Jafari Z, De Leon I, González MU, Huttel Y, Martínez L, et al. Composition-Dependent Cytotoxic and Antibacterial Activity of Biopolymer-Capped Ag/Au Bimetallic Nanoparticles against Melanoma and Multidrug-Resistant Pathogens. Nanomaterials. 2022; 12(5):779. https://doi.org/10.3390/nano12050779
Chicago/Turabian StyleNieto-Argüello, Alfonso, David Medina-Cruz, Yeremi S. Pérez-Ramírez, Sergio A. Pérez-García, Miguel A. Velasco-Soto, Zeinab Jafari, Israel De Leon, María Ujué González, Yves Huttel, Lidia Martínez, and et al. 2022. "Composition-Dependent Cytotoxic and Antibacterial Activity of Biopolymer-Capped Ag/Au Bimetallic Nanoparticles against Melanoma and Multidrug-Resistant Pathogens" Nanomaterials 12, no. 5: 779. https://doi.org/10.3390/nano12050779
APA StyleNieto-Argüello, A., Medina-Cruz, D., Pérez-Ramírez, Y. S., Pérez-García, S. A., Velasco-Soto, M. A., Jafari, Z., De Leon, I., González, M. U., Huttel, Y., Martínez, L., Mayoral, Á., Webster, T. J., García-Martín, J. M., & Cholula-Díaz, J. L. (2022). Composition-Dependent Cytotoxic and Antibacterial Activity of Biopolymer-Capped Ag/Au Bimetallic Nanoparticles against Melanoma and Multidrug-Resistant Pathogens. Nanomaterials, 12(5), 779. https://doi.org/10.3390/nano12050779

